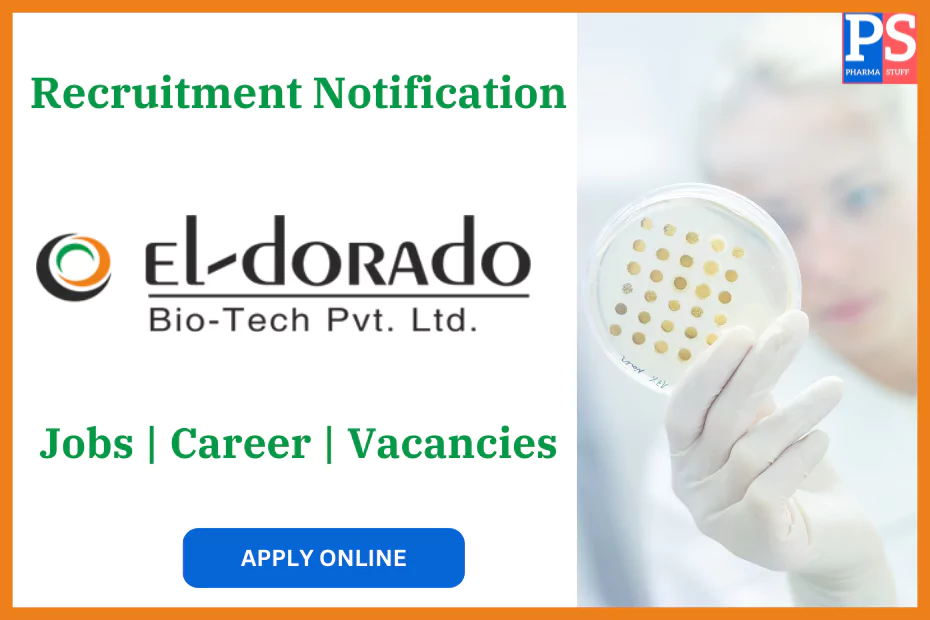
El-dorado Biotech Pvt. Ltd Career Recruitment - Job vacancies

Product Management Team (PMT) Executive Vacancies in Pune | El-dorado Biotech
- About El-dorado Biotech
- Job Role: PMT Executive
- Qualifications and Experience
- Location: Pune
- How to Apply
El-dorado Biotech is hiring PMT Executives in Pune to join their dynamic team. With 1-2 years of experience in sales, you can be a part of the company’s growth by driving innovative strategies and developing new products in the healthcare industry.
About El-dorado Biotech
El-dorado Biotech Pvt. Ltd. is a fast-growing company in the pharmaceutical sector, renowned for its cutting-edge products and innovative approaches to healthcare solutions. As part of its expansion, the company is seeking talented individuals to join its Product Management Team (PMT). This is a unique opportunity for those who wish to be at the forefront of product development, brand strategy, and marketing in the pharmaceutical industry.
Job Role: PMT Executive
As a PMT Executive at El-dorado Biotech, you will play a key role in shaping the company’s marketing strategies and contributing to new product development. You will collaborate closely with various departments, including medical affairs, to create promotional materials and campaigns that comply with industry standards. Here’s what your responsibilities will entail:
- Market Research: Conduct in-depth market research to understand trends, customer preferences, and competitive landscapes. Your insights will help develop actionable marketing strategies.
- Promotional Campaigns: Work with medical affairs and the marketing team to create engaging, compliant promotional materials that resonate with healthcare professionals and customers.
- Field Visits: Conduct field visits to meet healthcare professionals and gather real-world insights that will inform product and marketing decisions.
- Team Training: Organize training sessions to enhance the product knowledge and skills of the sales and marketing teams.
- Brand Planning: Provide valuable market insights to assist in strategic brand planning and help drive the growth of the company’s product portfolio.
- New Product Development: Contribute to the development of new products by identifying market gaps and customer needs.
This position is ideal for candidates who enjoy a mix of strategic planning, market research, and hands-on product management.
Qualifications and Experience
To apply for the PMT Executive position at El-dorado Biotech, candidates must meet the following requirements:
- Education: A graduate degree in science or pharmacy, with a relevant master’s degree in management.
- Experience: 1-2 years of experience in sales within the pharmaceutical or healthcare industry.
- Skills: Strong analytical and communication skills are essential, along with the ability to collaborate with cross-functional teams.
Location: Pune
The position of PMT Executive is based in Pune, Maharashtra.
How to Apply
If you meet the qualifications and are excited to work with El-dorado Biotech as a PMT Executive, don’t miss this chance! Interested candidates can send their updated resume to hr@eldoradobiotech.com or medicalaffairs@eldoradobiotech.com.
You must sign in to apply for this position.

